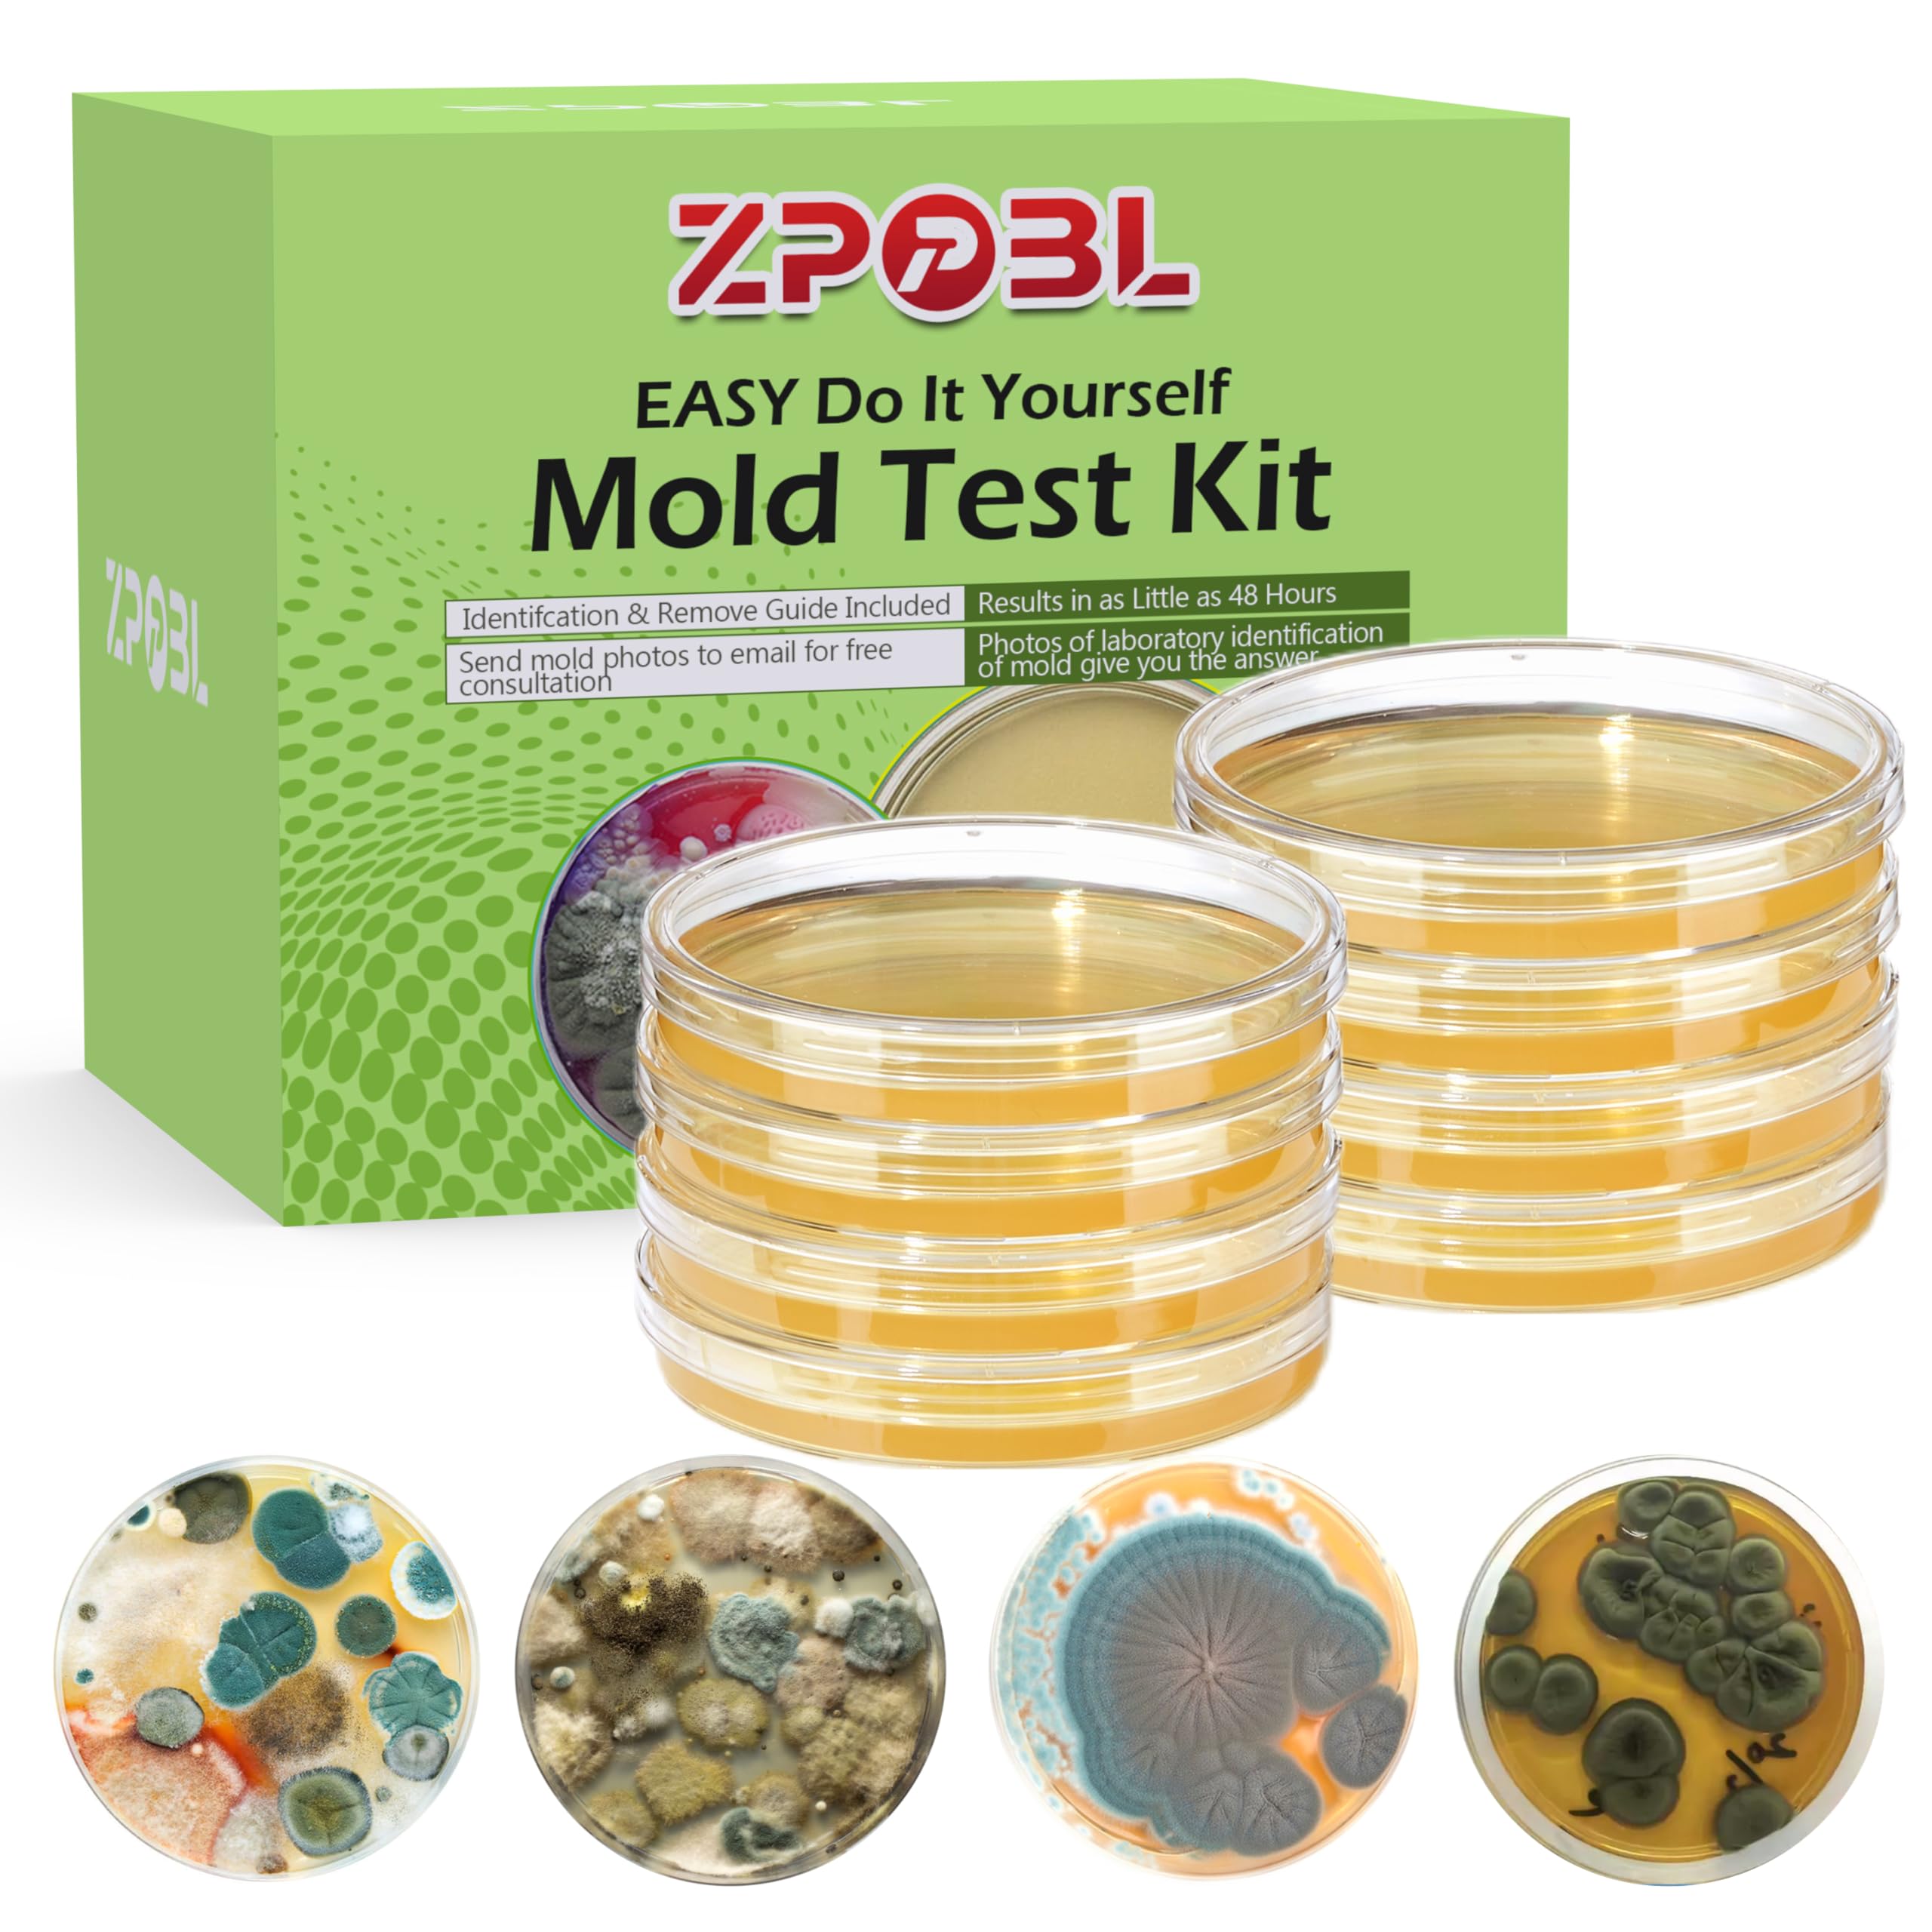

Zppbl
Kit De Prueba De Moho Zppbl 8 Pruebas Hogar | Lider Electrohogar
Anterior:$ 37.990
Precio: $ 30.990
18%
Visitar Lider Electrohogar
Prueba buscando otros productos en:
Historial de precios
Fecha
03 Feb
Precio
$ 30.990
Kit De Prueba De Moho Zppbl 8 Pruebas Hogar | Lider Electrohogar
$ 30.990
Visitar Lider Electrohogar
Características técnicas
Marca
Zppbl
Descripción
Kit de prueba de moho para el hogar - kit de prueba completo: nuestro kit de prueba de molde incluye 8 placas de prueba, una guía detallada del molde con instrucciones de extracción, 10 hisopos, hojas de etiquetas y guantes de prueba. todo lo que necesita para realizar pruebas de moho fáciles y completas en casa, sin necesidad de preparación adicional. - ubicaciones de prueba versátiles: este kit prueba aire interior, sistemas hvac, automóviles y varias superficies en su hogar u oficina. detecta moho en paredes, duchas, fregaderos, sistemas hvac y otras áreas húmedas para garantizar un entorno de vida seguro. - opciones de prueba flexibles: realice 8 pruebas separadas en diferentes ubicaciones o realice 2 pruebas en 4 áreas específicas. el kit viene en 2 paquetes independientes, lo que te permite volver a probar después de la eliminación del moho para verificar la efectividad de tus esfuerzos de limpieza. - identificación precisa del molde: con nuestra guía detallada de moldes y manual de extracción, puede identificar fácilmente el tipo de molde presente en su hogar comparando los resultados de las placas con las imágenes. si no está seguro, envíenos fotos y nuestro personal de laboratorio lo ayudará. - protección del área de alto riesgo: los muebles de madera son un caldo de cultivo común para el moho, especialmente el moho negro. utiliza este kit para revisar regularmente áreas de alto riesgo como armarios, armarios y camas, asegurando que permanezcan libres de moho y seguras para tu familia.
Marca
Zppbl
Descripción
Kit de prueba de moho para el hogar - kit de prueba completo: nuestro kit de prueba de molde incluye 8 placas de prueba, una guía detallada del molde con instrucciones de extracción, 10 hisopos, hojas de etiquetas y guantes de prueba. todo lo que necesita para realizar pruebas de moho fáciles y completas en casa, sin necesidad de preparación adicional. - ubicaciones de prueba versátiles: este kit prueba aire interior, sistemas hvac, automóviles y varias superficies en su hogar u oficina. detecta moho en paredes, duchas, fregaderos, sistemas hvac y otras áreas húmedas para garantizar un entorno de vida seguro. - opciones de prueba flexibles: realice 8 pruebas separadas en diferentes ubicaciones o realice 2 pruebas en 4 áreas específicas. el kit viene en 2 paquetes independientes, lo que te permite volver a probar después de la eliminación del moho para verificar la efectividad de tus esfuerzos de limpieza. - identificación precisa del molde: con nuestra guía detallada de moldes y manual de extracción, puede identificar fácilmente el tipo de molde presente en su hogar comparando los resultados de las placas con las imágenes. si no está seguro, envíenos fotos y nuestro personal de laboratorio lo ayudará. - protección del área de alto riesgo: los muebles de madera son un caldo de cultivo común para el moho, especialmente el moho negro. utiliza este kit para revisar regularmente áreas de alto riesgo como armarios, armarios y camas, asegurando que permanezcan libres de moho y seguras para tu familia.
Prueba buscando otros productos en:
Productos relacionados
Zinsser
Pintura Eliminador De Hongo Y Moho Zinsser Color Blanco 946G
$ 23.990
Ediciones Urano
Ediciones Urano - Libro Pruebas De Hechicería
$ 21.490
$ 23.001
7%de aumento.
Torriden
Kit De Prueba Dive-In Hidratante Torriden
$ 27.120
Torriden
Kit de Prueba DIVE-IN Hidratante Torriden
$ 21.696
$ 27.120
25%de aumento.





